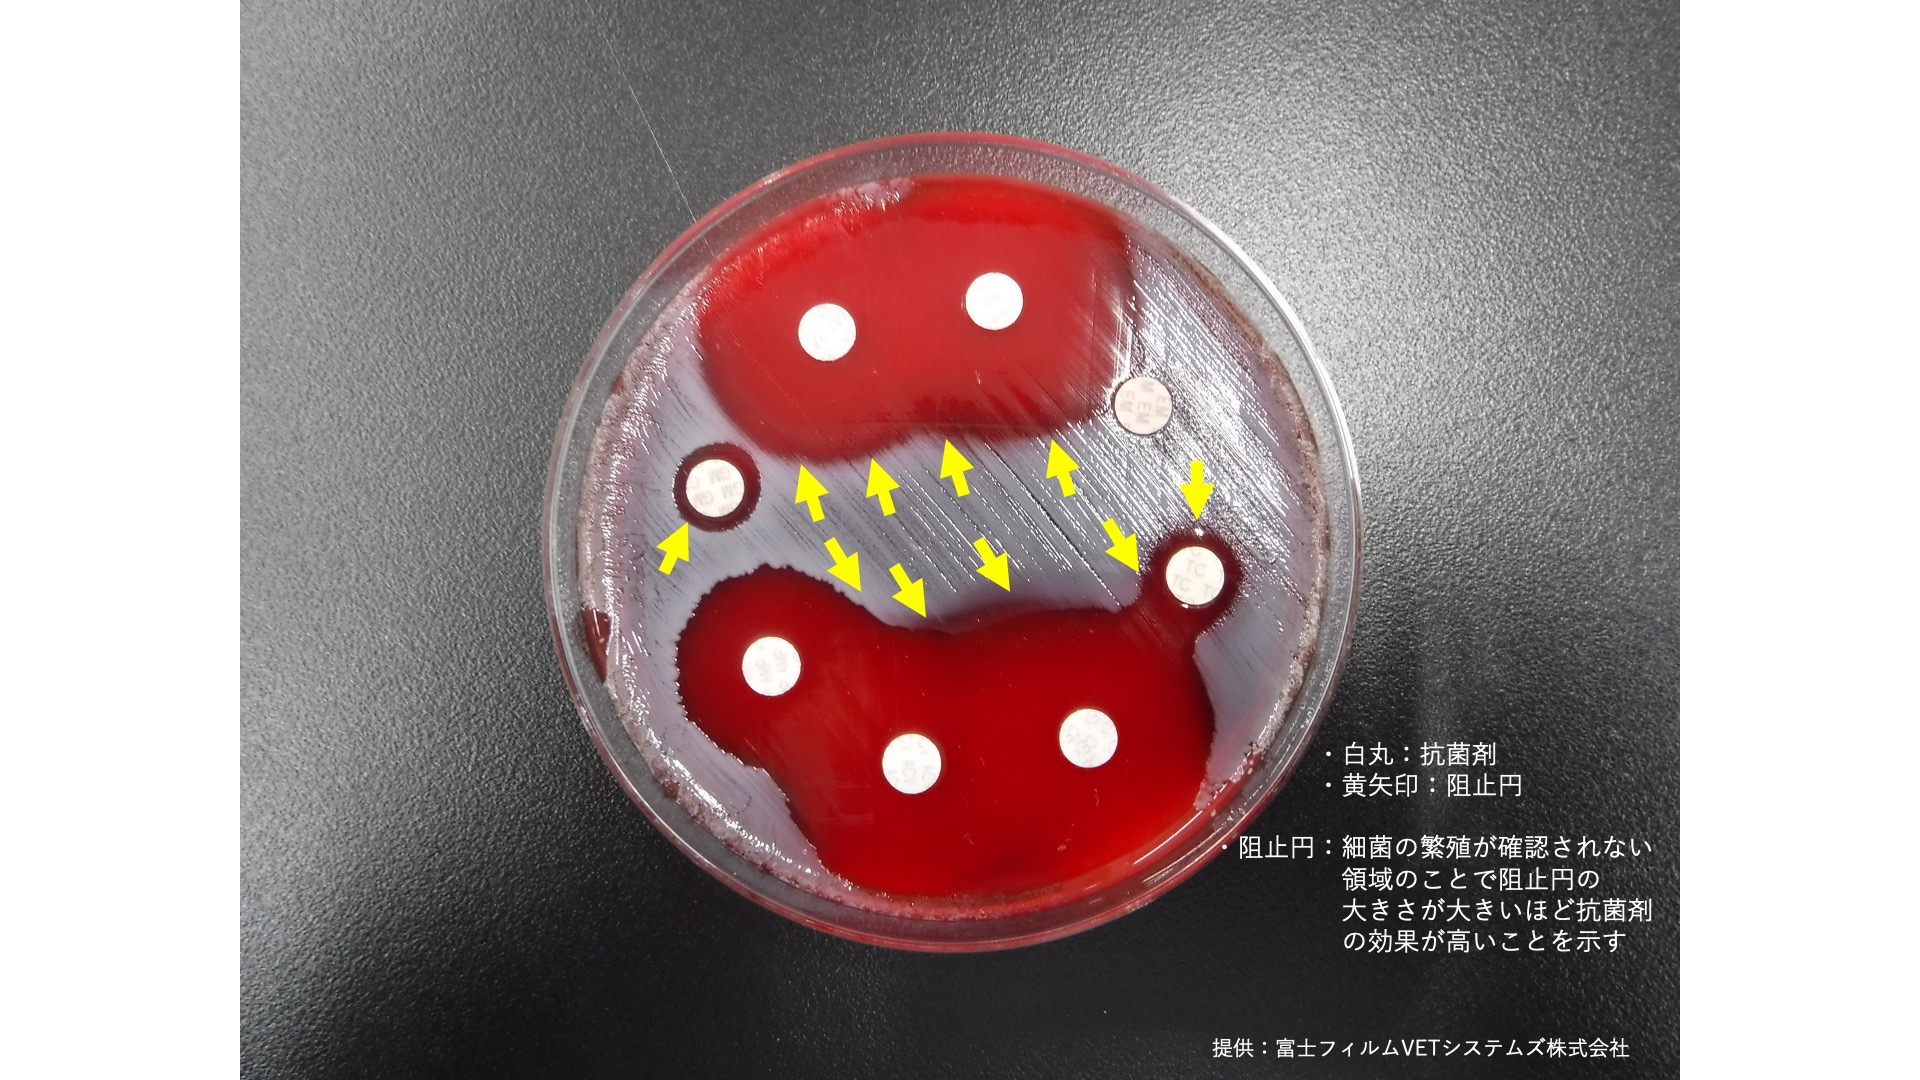

新入荷
再入荷
【あすつく】 犬と猫の細菌・真菌感染症診療 株式会社 緑書房 健康・医学
 タイムセール
タイムセール
終了まで
00
00
00
999円以上お買上げで送料無料(※)
999円以上お買上げで代引き手数料無料
999円以上お買上げで代引き手数料無料
通販と店舗では販売価格や税表示が異なる場合がございます。また店頭ではすでに品切れの場合もございます。予めご了承ください。
商品詳細情報
| 管理番号 |
新品 :62085241162
中古 :62085241162-1 |
メーカー | b26e26ec78af5 | 発売日 | 2025-04-30 03:56 | 定価 | 9800円 | ||
|---|---|---|---|---|---|---|---|---|---|
| カテゴリ | |||||||||
【あすつく】 犬と猫の細菌・真菌感染症診療 株式会社 緑書房 健康・医学
 犬と猫の細菌・真菌感染症診療 株式会社 緑書房,
犬と猫の細菌・真菌感染症診療 株式会社 緑書房, 緑書房 - 【新刊情報】 『犬と猫の細菌・真菌感染症診療 ~抗菌,
緑書房 - 【新刊情報】 『犬と猫の細菌・真菌感染症診療 ~抗菌, 犬と猫の日常診療のための抗菌薬治療ガイドブック | 原田 和記,
犬と猫の日常診療のための抗菌薬治療ガイドブック | 原田 和記, 犬も猫もお薬を飲むときがある!抗菌剤の用法用量を守りましょう定価12000円●状態:購入後目を通した程度で新品未使用に近い●カバー:あり●ヤケ:なし●ヨレ:なし●スレ:なし●折り目:なし●書き込み:なし●その他、注意事項:こちらの商品は即購入していただいて構いません。中古品ということをご理解の上ご検討ください。#獣医師 #獣医 #動物病院抗菌薬の適正使用のために必要な基礎知識と現場で役立つ実践的な内容を掲載。近年、薬剤耐性菌への関心が高まっており、抗菌薬の適正使用が求められている。本書では、感染症診療において知っておくべき基礎知識と、臓器ごとの代表的な疾患における疫学・診断法や抗菌薬の選択・使用法を含めた実践的な情報について解説。臨床感染症学とその関連疾患を理解することができ、獣医師はもちろんのこと、愛玩動物看護師にも役立つ情報が満載。【本書の特長】●感染症診療を行ううえで知っておきたい情報を整理した「基礎知識編」と、臓器ごとの代表的な疾患における疫学や診断法を解説した「実践編」の2部構成で、臨床感染症学とその関連疾患を理解できるようにわかりやすく解説。●「基礎知識編」では、グラム染色・顕微鏡の使い方などの検査技術、問題となる主な細菌や抗菌薬、薬剤耐性菌などの知識を解説。特に検査技術については、実務者である愛玩動物看護師・動物病院スタッフにもわかりやすいよう、基礎から解説。●「実践編」では、臓器ごとの検体の採取・処理方法から各疾患の疫学・診断・治療法にいたるまで整理・解説。抗菌薬が不必要な状況・疾患についても紹介し、抗菌薬適正使用の考え方が身につく。●特に重要な点がわかりやすいように工夫された紙面。●人医療・獣医療問わず、国内外延べ約650もの参考文献を掲載。エビデンスに基づいた情報を学ぶことができる
犬も猫もお薬を飲むときがある!抗菌剤の用法用量を守りましょう定価12000円●状態:購入後目を通した程度で新品未使用に近い●カバー:あり●ヤケ:なし●ヨレ:なし●スレ:なし●折り目:なし●書き込み:なし●その他、注意事項:こちらの商品は即購入していただいて構いません。中古品ということをご理解の上ご検討ください。#獣医師 #獣医 #動物病院抗菌薬の適正使用のために必要な基礎知識と現場で役立つ実践的な内容を掲載。近年、薬剤耐性菌への関心が高まっており、抗菌薬の適正使用が求められている。本書では、感染症診療において知っておくべき基礎知識と、臓器ごとの代表的な疾患における疫学・診断法や抗菌薬の選択・使用法を含めた実践的な情報について解説。臨床感染症学とその関連疾患を理解することができ、獣医師はもちろんのこと、愛玩動物看護師にも役立つ情報が満載。【本書の特長】●感染症診療を行ううえで知っておきたい情報を整理した「基礎知識編」と、臓器ごとの代表的な疾患における疫学や診断法を解説した「実践編」の2部構成で、臨床感染症学とその関連疾患を理解できるようにわかりやすく解説。●「基礎知識編」では、グラム染色・顕微鏡の使い方などの検査技術、問題となる主な細菌や抗菌薬、薬剤耐性菌などの知識を解説。特に検査技術については、実務者である愛玩動物看護師・動物病院スタッフにもわかりやすいよう、基礎から解説。●「実践編」では、臓器ごとの検体の採取・処理方法から各疾患の疫学・診断・治療法にいたるまで整理・解説。抗菌薬が不必要な状況・疾患についても紹介し、抗菌薬適正使用の考え方が身につく。●特に重要な点がわかりやすいように工夫された紙面。●人医療・獣医療問わず、国内外延べ約650もの参考文献を掲載。エビデンスに基づいた情報を学ぶことができる



























